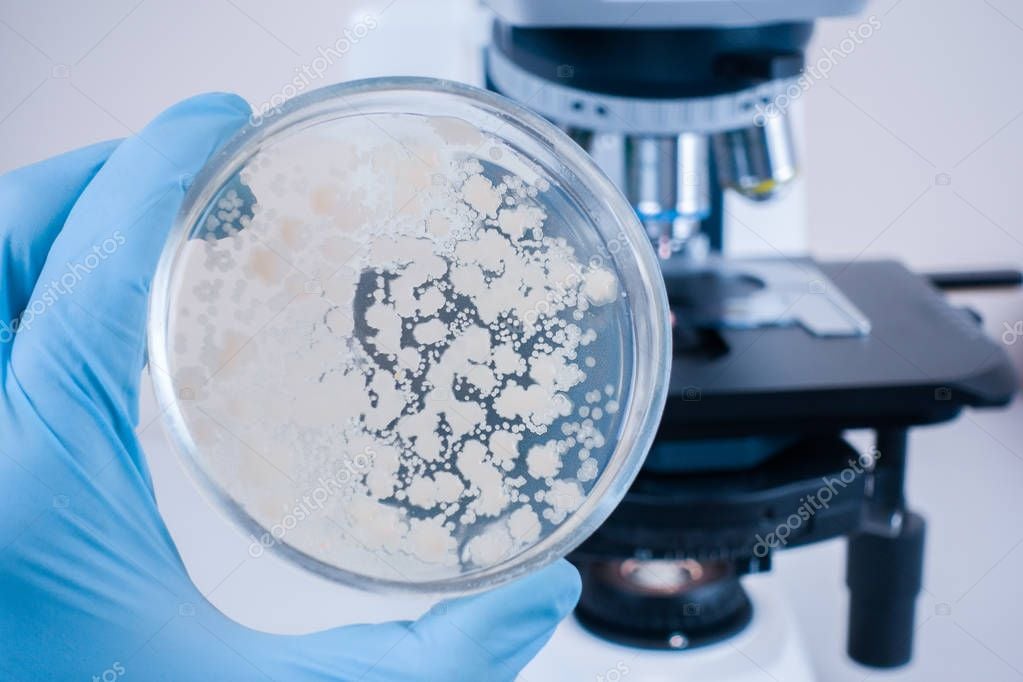
Antibiotico-resistenza, nuove linee guida per uso corretto dei farmaci

Antibiotico-resistenza, nuove linee guida per uso corretto dei farmaci
Aggiornate le raccomandazioni per contrastare la resistenza batterica.
L’antibiotico-resistenza si conferma tra le principali emergenze sanitarie a livello globale. L’uso improprio e spesso indiscriminato degli antibiotici favorisce la selezione di batteri resistenti, rendendo le infezioni sempre più difficili da trattare e aumentando il rischio di complicanze, ricoveri prolungati e mortalità.
Le più recenti linee guida internazionali e nazionali indicano con chiarezza la strada da seguire: prescrizioni mirate basate su diagnosi accurate, scelta dell’antibiotico appropriato, rispetto rigoroso dei dosaggi e della durata della terapia. Viene inoltre ribadita l’importanza di evitare l’automedicazione e l’interruzione precoce dei trattamenti, pratiche che contribuiscono in modo significativo alla diffusione di ceppi batterici resistenti.
Una corretta applicazione delle raccomandazioni cliniche potrebbe ridurre sensibilmente il numero di infezioni resistenti, preservando l’efficacia degli antibiotici per le future generazioni. La sfida riguarda non solo i professionisti sanitari, ma anche i cittadini, chiamati a un uso consapevole e responsabile dei farmaci.
In Calabria, dove la tutela della salute pubblica rappresenta una priorità strategica, promuovere campagne di informazione e rafforzare l’educazione sanitaria diventa fondamentale per contrastare un fenomeno che minaccia l’intera collettività. La lotta all’antibiotico-resistenza è una responsabilità condivisa che richiede impegno, formazione e collaborazione tra istituzioni, operatori sanitari e cittadini.
Written by
Redazione 2


